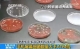
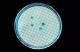

央视曝光:比马桶还脏东西,你却天天拿着吃饭!
- 2019-03-29 09:25:00
- 佘金锁 原创
- 0
在生活中最接近你的是什么?
很多人会说是家人,丈夫或者朋友, 但都不是。事实上,生活中最贴近你的 实际上就是你的 手机!
不知道你是否已经发现,无论你走到哪里, 手机现在已成为你的出门必不可少的东西。
跟朋友聊会语音
TA蹬鼻子上脸
吃着东西刷手机
TA顺势入口
当晚上趴在被窝刷手机时
TA与你一同入睡
CCTV-13新闻频道曾经报道
手机的细菌数量是马桶的18倍!!!
手机表现的细菌更是高达120000/cm²!
显微镜下的手机,到底有多脏!
在显微镜下,手机的最真实外观呈现
在每个人面前。随着镜片的不断扩大, 一些细菌清晰可见。
可以看出上面有很多细菌,种类也很多样。
这也使许多网友产生怀疑。
如果每隔三到五次用酒精消毒, 那会不会好一点呢?
你可以看到消毒后的样子, 其实跟以前没什么大的区别。
你有没有想过,如果你上厕所你也带着手机, 那么你就会在上面沾染很多细菌,然后把它 放在吃饭的地方,这样一想你还能接受吗?
手机上最常见的细菌
科学家在2009年的一项研究中发现, 因为手机会和面部、耳朵、嘴唇和手都有接触, 而且使用手机的人健康状况也不一样,因此, 手机早已成为了一个名副其实的病原体储存器。
那么,手机里到底有哪些常见的细菌呢?
以上信息来源:搜狐网
1. 大肠菌群
大肠菌群总是存在于人类和动物的粪便和植物的土壤中。现在,大肠菌群也毫不掩饰地存在于个人的手机上。尽管少量的这类细菌不会让你生病,但它们的存在意味着其它病原体也潜伏在手机上。
2. 大肠杆菌
大肠杆菌通常存在于人类的肠道之中,若这种细菌存在于手机上意味着有其它污染物的存在。此外,手机上可能会存在一种O157:H7血清型的大肠杆菌菌株。虽然它们的存在非常罕见,但正是这种病原体导致了我们在电影和当地新闻广播中听到的食源性疾病的发生。
3. 金黄色酿脓葡萄球菌
金黄色酿脓葡萄球菌是另一种常见的细菌,它的伤害性也依据菌株的不同而有差异。有的菌株会导致葡萄球菌感染等严重的皮肤疾病。比如,耐甲氧西林金黄色葡萄球菌就会导致皮肤痛疖,而且,这种细菌就是通过皮肤接触传播的。通常这种细菌在医院、医疗中心等地传播,而使用脏兮兮的手机无疑加快了这一过程。
远离细菌,手机日常消毒方法
一周消毒一次
利用消毒液、75%的医用酒精、紫外线消毒灯可达到为手机消毒的目的。每周用沾有医用酒精的棉签轻轻擦拭手机机身,注意等酒精完全挥发后再使用手机,以免引发手机短路。
尽量不外借手机
不鼓励交换手机使用,手机尽量不外借,减少手机传播病菌的渠道。家中有抵抗力差的老弱患者,应将其手机消毒后再给其使得。探视患者时,不要使用患者手机。
其他生活小习惯
人们在通话或收发短信时,尽量不要取用其他物品,特别是不要取用食物。平时也可以使用耳机通话,这样可以减少面部和口唇部位与手机的接触,减少细菌侵害。
翼猫科技 专注家庭健康管理
让您享寿健康人生!
部分素材来源于网络,如涉侵权联系删除
文:Judy 设计:Yokie